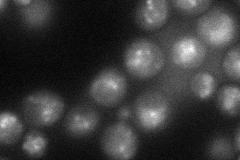
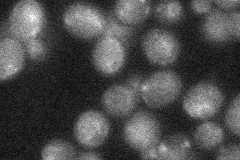
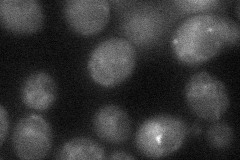
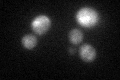

View description
Ankyrin repeat-containing protein similar to Akr1p; member of a family of putative palmitoyltransferases containing an Asp-His-His-Cys-cysteine rich (DHHC-CRD) domain; possibly involved in constitutive endocytosis of Ste3p
Localization:
Intensity:
Fold change:
Significance:
-
C’ GFP library in SD

cytosol21.03 -
N' NOP1pr-GFP in SD
punctate,mitochondria56.5762 -
N' TEF2pr-mCherry in SD

vacuole38.3454 -
N' NATIVEpr-GFP in SD
punctate,vacuole membrane25.6051 -
N' TEF2pr-VC and Cyto-VN in SD
below threshold29.2401 -
C’ GFP library in SD+DTT
cytosol22.51.06No -
C’ GFP library in SD+H2O2

cytosol22.881.08No -
C’ GFP library in Starvation Media

cytosol17.290.82No -
C’ GFP library on the background of Pup2-DaMP

cytosol -
C’ GFP library on the background of CCT mutant

cytosol22.38041.06398No
